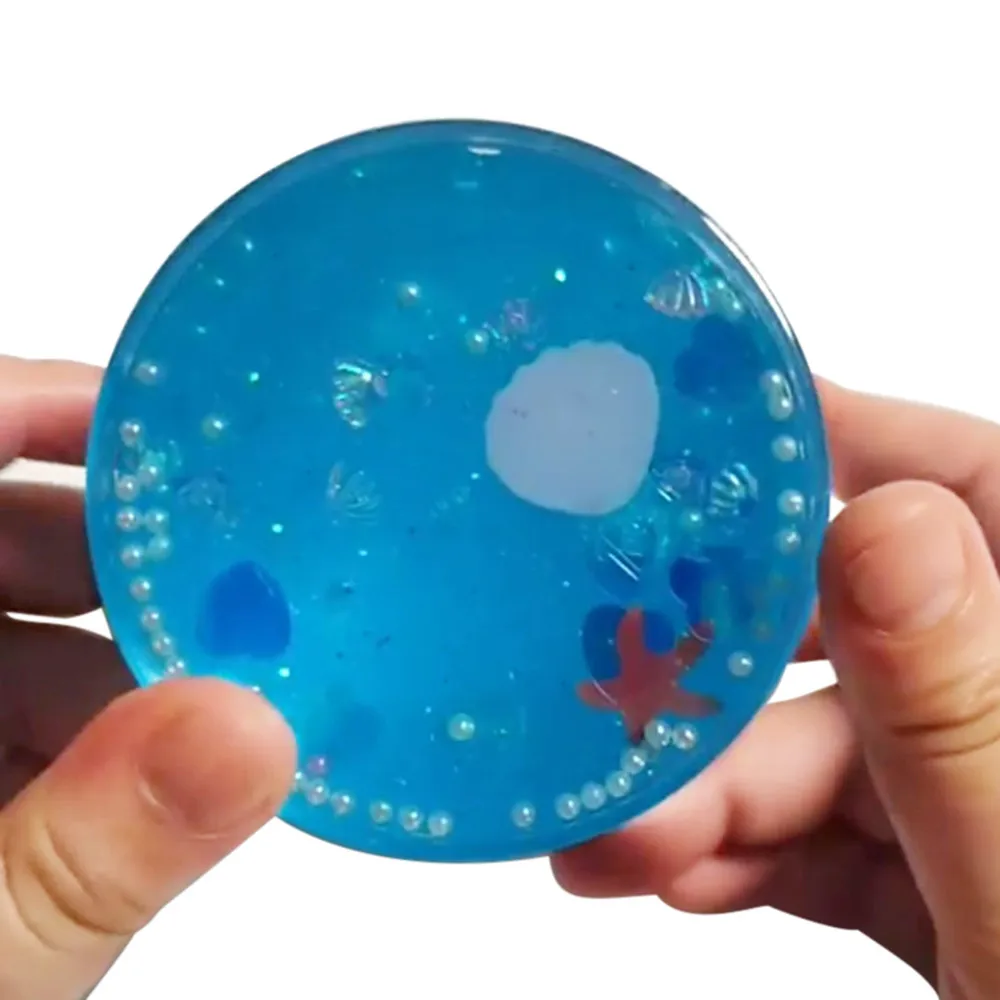

60 мл Безопасный и нетоксичный удивительный пушистый слизь морской мир
Сохраните в закладки:







История цены
*История изменения цены! Указанная стоимость возможно, уже изменилось. Проверить текущую цену - >
| Месяц | Минимальная цена | Макс. стоимость | Цена |
|---|---|---|---|
| Sep-14-2025 | 0.20 руб. | 0.93 руб. | 0 руб. |
| Aug-14-2025 | 0.57 руб. | 0.98 руб. | 0 руб. |
| Jul-14-2025 | 0.88 руб. | 0.84 руб. | 0 руб. |
| Jun-14-2025 | 0.52 руб. | 0.77 руб. | 0 руб. |
| May-14-2025 | 0.95 руб. | 0.84 руб. | 0 руб. |
| Apr-14-2025 | 0.45 руб. | 0.44 руб. | 0 руб. |
| Mar-14-2025 | 0.74 руб. | 0.89 руб. | 0 руб. |
| Feb-14-2025 | 0.95 руб. | 0.11 руб. | 0 руб. |
| Jan-14-2025 | 0.9 руб. | 0.49 руб. | 0 руб. |
Новые товары
2021 Лидер продаж новинка 120 мл антипригарная большая пенная глина игрушки для
100 мл многоцветная мгновенной проявки Macaroon пушистый слизистый Пластилин Squeeze
Новое поступление мягкий пушистый слайм шоколадное печенье подвески масляная
4 шт. прозрачный слайм из пеноматериала для творчества игрушечные шарики 0 1-0 18
Мягкие фрукты DIY Поставки слаймов Pack пушистый слайм наборы ароматерапия давление
Diy масляные слаймы мягкие эластичные и не липкие с облаками Набор для
Набор для лепки теста "Волшебная пекарня" 100г аксессуары игра моделирования цвет щенок Пластилин Слайм Кит творчество детский игрушка подарок ремесло.
Русский перевод названия товара: Набор фигурок из полимерной глины "Фруктовые кусочки" диаметром 5 мм для декорирования игрушек, наполнения, украшения грязью с фруктовыми мотивами арбуза, киви и апельсина для детей.
Характеристики
60 мл Безопасный и нетоксичный удивительный пушистый слизь морской мир
Описание товара
60 мл Море мир смешивания облако слизи шпатлевка Ароматические стресс дети глина игрушка
Описание:
Отличное снятие стресса для взрослых и детей Будут отправлены небольшие детали в случайном порядкеПодходит для детей старше 8 лет Безопасный и нетоксичный-без буры используется в этой слизи
Идеально подходит для художественных, ремесленных и школьных проектов
Потрясающая пушистая слизь и очень весело играть!Упаковка продукта:
1 шт. 60 мл игрушка слизи


Трекер стоимости
Отзывы покупателей
Новые отзывы о товарах
Нисколько не пожалела, что заказала здесь светоотражающий Зонт Godox. СТоимост оказалась вполне доступной. Просто в других интернет-магазинах видела такой же... Читать отзыв полностью...
Просто невероятно элегантное платье, если сказать буквально в нескольких словах. По факту оно оказалось еще лучше, чем на фотографии на... Читать отзыв полностью...
ZPW Ebike Store продавец мошенник! в чате сообщает, что все хорошо, товар есть. далее пишет, что много заказов и надо... Читать отзыв полностью...
Отличный магазин для рыбаков. Взял тут спиннинг и набор снастей, персоналы помогли с тонкостями выбора, цена нормальная по рынку, доставка... Читать отзыв полностью...

Какая цена этого товара?Могу ли я купить и получить этот товар с доставкой в РФ г ВОЛГОГРАД.Оплата б/к" МИР".... Читать отзыв полностью...